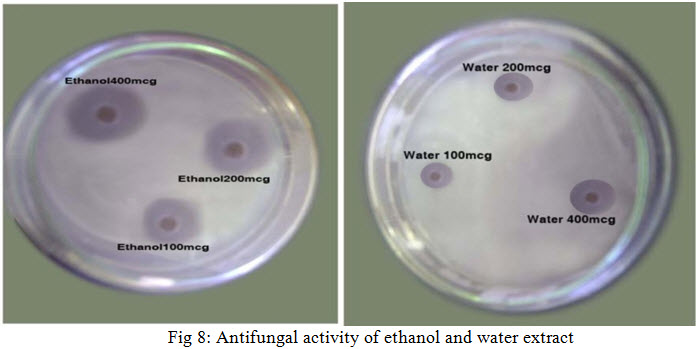

{ DOWNLOAD AS PDF }
ABOUT AUTHORS
SANDHIYA.V*1, KAVITHA.C2
1 Department of Pharmaceutics, C.L.Baid metha College Of Pharmacy, Thoraipakkam, Chennai, India
2 Department of Pharmacognosy, C.L.Baid Metha College Of Pharmacy, Thoraipakkam, Chennai, India
*sandhiyavaithi@gmail.com
ABSTRACT
The leaves of Azima tetracantha belongs to salvadoraceae family, commonly known as “mulluchangu” in tamil, it is a best known medicinal plant from ancient period. The plant has reported for many pharmacological action such as antifungal, antibacterial, hepatoprotective, anti inflammatory, anti ulcer, anti arthritic, hypolipidemia etc. The present study was investigated about the characteristics, quantitative estimation and antifungal activity of Azima tetracantha leave in different solvents extract (hexane, chloroform, ethanol, ethyl acetate and water) successfully. In quantitative estimation the leaves of Azima tetracantha shows 48.4 % yield of carbohydrate in water extract, 21% yield of phenol in ethanol extract and 24% in ethyl acetate extract and 19% yield of tannin in ethanol extract. In antifungal activity of Azima tetracantha leave two standard drugs are used such as clotrimazole (10 mcg/m1 as standard-1) and ketaconazole (10 mcg/ml as standard -2). The antifungal activity was studied for all extracts in a concentration of 100 mcg/ml, 200 mcg/ml and 400mcg/ml against Candida albicans and Aspergillus niger. The Ethanol extract of a leave of Azima tetracantha in increasing concentration shows prominent activity against Candida albicans compared to other extract. The Hexane, Chloroform and Water extracts of a leave of Azima tetracantha shows moderate activity against Candida albicans compared to ethyl acetate extract. The Ethyl acetate extract shows slight activity against Candida albican scompare to other extracts. There was no activity was observed for various extracts of Azima tetacantha against Aspergillus niger.
[adsense:336x280:8701650588]
REFERENCE ID: PHARMATUTOR-ART-2436
|
PharmaTutor (ISSN: 2347 - 7881) Volume 4, Issue 10 Received On: 24/03/2016; Accepted On: 12/05/2016; Published On: 01/10/2016 How to cite this article: Sandhiya V, Kavitha C; Quantitative estimation of Secondary Metabolite and Inhibitory effect of Azima Tetracantha leave extract against Candida Albicans; PharmaTutor; 2016; 4(10); 37-42 |
INTRODUCTION
Medicinal plants are still used in major parts of developing countries as traditional medicinal systems to cure many infectious diseases with herbal remedies throughout the history of mankind. Even today, plant materials continue to play a major role in primary health care as therapeutic remedies in many parts of the world [1] Azima tetracantha a naturally occurring as spiny, evergreen shrub with a tendency to scramble. Grows up to 2 meters in height with 2 spines 0.5 x 5 cm long in each leaf axil, sometimes scandent with stems up to 8 m long.Branchlets are blue-green, of tendensely hairy; with four sharp and axillary spines up to 50 mm long. Leaves are simple, opposite, elliptic, acute, sessile shiny and surrounded by 4 sharp thorns. Stipules absent or rudimentary; petiole short; blade elliptical oblong to ovate-oblong or orbicular, base rounded or somewhat narrowed, apex mucronate, pinnately veined with one pair of lateral veins from near the base. Inflorescence an axillary, sometimes terminal spike or cyme up to 3 cm long or flowers solitary; bracts ovate, often with long and spinousmucro. Flowers unisexual, regular, 4-merous, usually sessile; male flowers with stamens inserted at the base of the rudimentary ovary, exserted; female flowers with staminodes and superior ovary, up to 4.5 mm long with a broad sessile stigma. Fruits are round, small, and yellow to white when ripe. Seeds disc-like, brown to black(2)The plant is considered as a powerful diuretic and is also used to treat rheumatism, dropsy, dyspepsia, diarrhoea and as a stimulant tonic for women after confinement (3). It is also used as food for various herbal medicines in Africa, India and Madagascar(4) . Locally, the traditional healers from Tirunelveli district of Tamil nadu use the root bark (Paste with butter milk) as potent remedy for jaundice. This plant has been reported to possess different biological activities like antiinflammatory, wound-healing, diuretic and analgesic activities(5) . The present study is aimed at Screening of Phytochemical and Antimicrobial activities of Azima tetracantha leaves.

Fig 1: AZIMA TETRACANTHA PLANT
COLLECTION AND AUTHENTIFICATION OF PLANT MATERIAL
The leaves of Azima tetracantha were collected from the Sengottai, Tirunelveli, Tamil Nadu, India in the month of October 2009. The plant material was identified and authenticated by Mr. V.Chelladurai, Retired Research officer-botany, C.C.R.A.S. Govt. of India, Tirunelveli. The Collected plant material was free from diseases and also free from contamination of other plants
PREPARATION OF EXTRACTS
The Freshly collected plant material was dried in shade andthen coarsely powdered in a blender.
The coarse powder was successively extracted in an aspirated bottle with n-Hexane, Chloroform, Ethyl acetate, Ethanol and Water for about 72, 48 and 24 hours by maceration technique.After decantation, filtered through the Whatmann filter paper No.41and Solvents are distilled and concentrated. The Concentrated extracts was used for further studies
Table 1: CHARACTERISTICS OF VARIOUS EXTRACTS OF Azima tetracantha
|
EXTRACT |
HEXANE |
CHLOROFORM |
ETHYL ACETATE |
ETHANOL |
WATER |
|
COLOUR |
Dark green |
Blackish green |
Blackish green |
Dark brown |
Brown |
|
CONSISTENCY |
Slimy |
Sticky |
Greasy |
Sticky |
Sticky |
QUALITATIVE ESTIMATION OF PRIMARY AND SECONDARY METABOLITE
CARBOHYDRATE ESTIMATION
Working standard: Dilute 1ml of stock solution (1 mg of glucose in 10 ml of distalled water) to 10 ml with distilled water
Preparation of Sample(6): About 100mg of the (Water extract) was hydrolyzed by boiling with 100ml of 2.5N HCL for 3 hrs and then cooled to room temperature. This mixture was then Neutralized using solid sodium carbonate until the effervescence ceases and the volume was made up to 100ml and centrifuged. The supernatant was separated and used for estimation.
Procedure
Pipette out 0.2, 0.4, 0.6, 0.8 and 1 ml of the working standard into a Series of test tubes and Pipette out 1 ml of supernatant with triplicates in 3 other test tubes .Make up the volume to 1 ml with distilled water in all test tubes. A tube with 1 ml of water serves as the blank.4 ml of anthrone reagent was added and heated for 8 minutes in water bath and Cool. The green colour developed was read at 630 nm. A standard graph of glucose was plotted, from which the Carbohydrate content of the (alcoholic and hydroalcoholic extract) was determined. The results were shown in Table no. 2 and Figure no. 2.
TOTAL PHENOL ESTIMATION
Working standard: Dilute 1 ml of the stock solution(10 mg of gallic acid was dissolved in 10 ml of methanol) to 10 ml with methanol in a Standard flask. 1 ml of this solution contains 100μg Tannins.
Preparation of extract: - 10 mg of (Ethyl acetate and Ethanol) extracts was weighed and dissolved in 10 ml of methanol water (70:30). From this 1 ml was used for estimation.
Procedure(7): Pipette out 0.1, 0.2, 0.3, 0.4and 0.5 ml of the working standard into a series of test tubes. Pipette out 1 ml with duplicates of sample extracts in two other test tubes. The volume was made up to 1 ml with methanol. 1 ml of water serves as the blank. To this 5 ml of folins phenol reagent (1:2) followed by 4 ml of 7.5% sodium carbonate was added and kept at room temperature for 1.5 hr. Blue colour was formed. The colour intensity was read at 765 nm. A standard graph of Gallic acid was plotted, from which the phenol content of the (Ethyl acetate and Ethanol) extract was determined. The results were shown in Table no.2 and Figure no.3.
TOTAL TANNIN ESTIMATION
Working standard: Dilute1ml of stock solution (10 mg of tanicacia in 10 ml of distalled water) to 10ml with distilled water in a standard flask. 1 ml of this solution contains 100μg Tannins.
Preparation of sample: 10mg of (Ethanolic extract) was weighed and dissolved in 10ml of methanol: water (70:30). From this 1ml was used for estimation.
Procedure
Pipette out 0.2, 0.4, 0.6, 0.8, and 1.0 ml of working standard into a series of test tubes. Pipette out 1 ml of the extract in duplicates. The volume was made up to 1 ml with distilled water, 1 ml of water serves as the blank. To this 0.5ml folin’s phenol reagent(1:2) followed by 5ml of 35% w/v sodium carbonate were added and kept at room temperature for 5 min. Bluecolour was formed. The colour intensity was read at 640nm. The results were shown in Table no.2 and Figure no.4
TABLE 2: QUANTITATIVE ESTIMATION OF SECONDARY METABOLITE
|
Selected Metabolites |
Ethanol |
Ethyl Acetate |
Water |
|
Carbohydrate |
-- |
-- |
48.4% |
|
Tannin |
19% |
-- |
-- |
|
Phenol |
21% |
24% |
-- |


NOW YOU CAN ALSO PUBLISH YOUR ARTICLE ONLINE.
SUBMIT YOUR ARTICLE/PROJECT AT editor-in-chief@pharmatutor.org
Subscribe to Pharmatutor Alerts by Email
FIND OUT MORE ARTICLES AT OUR DATABASE
DETERMINATION OF ANTIFUNGAL ACTIVITY
The anti-fungal studies were carried out on Sabouraud’s Dextrose Agar (SDA) of hi-media laboratories to cultivate the fungal strains, for antifungal activity two fungal strains are used such as Aspergillus niger and Candida albicans.
PROCEDURE
Cultivation of fungi :Sabouraud’s dextrose agar slants were prepared, in which aseptic cultivation of aspergillus niger and Candida albicans was done about weeks’ time.
Table 3: Preparation of Sabouraud’s dextrose agar slant(8)
|
s.no |
ingredients |
Qty(g/L) |
|
1 |
D(+)-Glucose |
40,00 |
|
2 |
Meat peptone |
5,00 |
|
3 |
Casein peptone |
5,00 |
|
4 |
Agar |
15,00 |
Dissolve 65 g in 1 L of distilled water and bring to the boil stirring frequently. Distribute into final containers and sterilize in the autoclave at 121°C for 15 minutes.
Inoculation of fungi
The fully-grown fungal mat from the fresh cultures of fungi was used for inoculation. A loopful of fungi from the SDA plant was inoculated in to 250ml of sterilized SDA medium and shake well. It was then poured into sterile Petri plates and allowed to solidify. With the help of sterile cork borers, 8mm diameter wells were cut out on the fungi seeded SDA medium.0.1ml of the various extract concentration were dropped into each, appropriate labelled well. The plates were incubated for 1hr at room temperature and incubated at 37ºc for 48hrs. Antifungal activity was determined by measuring the diameter of zones of inhibition (mm) produced after incubation. Ketaconazole and Clotrimazole were used as standard. The results were shown in Table no. 3 and Figure no.5, 6, 7 and 8.
Table 3: Antifungal Activity of various extracts of Azima tetracantha against Candida albicans
|
S.NO.
|
Concentration (Mcg/ml) |
ZONE OF INHIBITION(MM) |
||||
|
HEXANE |
CHLOROFORM |
ETHYL ACETATE |
ETHANOL |
WATER |
||
|
1 |
100 |
10 |
11 |
9 |
12 |
10 |
|
2 |
200 |
13 |
14 |
10 |
15 |
13 |
|
3 |
400 |
16 |
17 |
11 |
19 |
15 |
|
4 |
Standard1(Clotrimazole)(10mcg/ml) |
24 |
24 |
24 |
24 |
24 |
|
5 |
Standard-2(Ketaconazole) (10mcg/ml) |
22 |
22 |
22 |
22 |
22 |
|
6 |
Control(DMSO) |
- |
- |
- |
- |
- |
PHOTOGRAPHS OF SCREENING OF ANTIFUNGAL ACTIVITY WITH DIFFERENT EXTRACTS AGAINST Candida albicans

DISCUSSION
The characteristics of a leave of Azima tetracantha such as colour and consistency were determined by visual method .The result was shown in Table no.1.
The quantitative estimation of a leave of Azima tetracantha were investigated. The primary metabolite (Carbohydrates) are positively reported in water extract, which shows green colour at 630nm and the yield was found to be 48%. The results were shown in Table no.2 and Figure no.2.
The secondary metabolite Phenols are positively reported in ethanol and ethyl acetate extract,which shows blue colour at 765nm and the yield was found to be 21% in ethanol extract and 24% in ethyl acetate extract. The results were shown in Table no.2 and Figure no.3.
Tannins are positively reported in ethanol extract,which shows a blue colour at 640nm and the yield was found to be 19% in ethanol extract.The results were shown in Table no.2 and Figure no.4.
The anti-fungal activityof leave of Azima tetracantha were determined in all extracts ( hexane, chloroform, ethyl acetate, ethanol and water ) succesfully at different concentration (100, 200, 400mcg/ml) .The results were shown in Table no.3 and Figure no. 5, 6, 7 and 8.
The Ethanol extract of a leave of Azima tetracantha in increasing concentration shows prominent activity against Candida albicans compared to other extract.
The Hexane, Chloroform and Water extracts of a leave of Azima tetracantha shows moderate activity against Candida albicans compared to ethyl acetate extract. The Ethyl acetate extract shows little activity against Candida albicans compare to other extracts
There was no activity was observed for various extracts of Azima tetacantha against Aspergillus niger.
CONCLUSION
The quantitative and antifungal activity was carried out successfully; the activity was seen using different solvent. Compared to other solvent extract the ethanol extract shows increasing activity as increase in the concentration, may be due to the increase in the oxidatsion process of ethanol extract on the cell wall of Candida albicans. In future it would be a most prominent herbal medicine for many ailments.
REFERENCES
1. Sukanya SL., Sudisha J., Hariprasad P., Niranjana SR., Prakash HS., Fthima SK., Antimicrobial activity of leaf extracts of Indian medicinal plant against clinical and phytopathogenic bacteria; Afr. J. Bio; 2009; 8(23); 6677-6682.
2. K. RKiritikar ; Indian Medicinal Plants; Second Edition, Delhi; Voume 2; 1987.
3. K.M Nadkarni; Indian Meteria Medica; Popular Prakhasa; Bombay; 1976
4. Bennet R N; Mellon F A ; Rosa E A; Perkins L and Kroon PA; Profiling flavanoids, alkaloids and other secondary metabolite in tissue of Azima tetracantha; J. Agri. food chemistry; 2004 ; 52(19); 5856-5862 .
5. Nandgude TD; Bhojwani AP; Kinage Krishna; Analgesic activity of various extract of leaves of Azima tetracanthaLam; Intl. J. Green. Pharm; 2007; 1(1); 37-38.
6. D.C Garret; The quantitative analysis of drugs; niraliprakash; Japan; 1964.
7. M.EMace; Histochemical localization of phenols in health phytopathlogy; delhi;1963.
8. L. AJELLO; Cultural Methods for Human Pathogenic Fungi J; ChronDis; Delhi; 1957.
NOW YOU CAN ALSO PUBLISH YOUR ARTICLE ONLINE.
SUBMIT YOUR ARTICLE/PROJECT AT editor-in-chief@pharmatutor.org
Subscribe to Pharmatutor Alerts by Email
FIND OUT MORE ARTICLES AT OUR DATABASE

